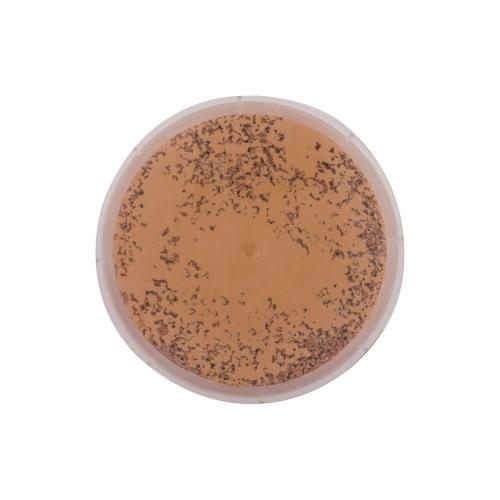

Cumpără Physicians Formula Mineral Wear Cushion Foundation SPF50 14 ml fond de ten tester pentru femei Medium

Physicians Formula Mineral Wear Cushion Foundation SPF50 14 ml fond de ten tester pentru femei Medium. Physicians Formula Mineral Wear Cushion Foundation SPF50 Fond de ten pentru femei 14 ml Nuanţă Medium tester